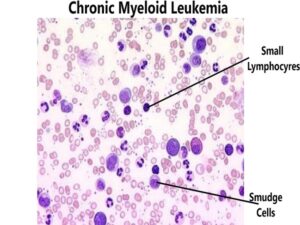
Chronic Myeloid Leukemia

Chronic Myeloid Leukemia Cml in India
Chronic Myeloid Leukemia (CML) is blood-cell cancer that begins in the blood-forming cells of the bone marrow. It mostly affects older adults.
Depending on the severity and age factor, doctors may recommend chemotherapy, drug therapy, biological therapy followed by bone marrow transplant.
Hematologists who specialize in diagnosing and treating blood disorders, treat Chronic Myeloid Leukemia (CML) well.
A complete blood count (CBC) test, when predicting the high levels of white blood cells, confirms the presence of Chronic Myeloid Leukemia (CML) in the blood.
The five-year survival rate for Chronic Myeloid Leukemia (CML) patients is 69%.
Nowadays, drug therapy is quite effective as compared to bone marrow transplant for treating Chronic Myeloid Leukemia (CML) as the surgical treatment holds a lot of side-effects.
Get Opinion From Doctor
We offers these Services
- Providing a doctor’s opinion and proper quotation
- Selecting the best hospital and doctor as per your case
- Arranging a call with the doctor (if the case required)
- Visa assistance, Providing Visa Invitation Letter (VIL)
- Providing full guidance how to get Visa from your country
- Providing total cost including treatment, air tickets, accommodation, and food
- Assitance to book flight ticket from your country
- Arranging airport pick up/ drop
- Providing professional language interpreter
- Booking accommodation and guest house as per your budget/ prefrence
- Providing help in money exchanging
- Providing local sim card
- Arranging video consultation with specialist doctor if case requires
BLK-Max Super Speciality Hospital
Number of beds: 700
ICU Beds: 175
Airport Distance: 13 Km
Brief About:
- BLK Super Speciality Hospital was established by Dr. B.L. Kapur in 1959. It was inaugurated by the then Prime Minister of India, Pandit Jawahar Lal Nehru.
- BLK Super Speciality Hospital was established by Dr. B.L. Kapur in 1959. It was inaugurated by the then Prime Minister of India, Pandit Jawahar Lal Nehru.
- BLK has a unique combination of the best in class technology, put to use by the best names in the professional circles to ensure world-class health care to all patients.
Indraprastha Apollo Hospital
No. of beds: 900
ICU Beds: 262
Airport: 20kms
Brief About:
- Indraprastha Apollo Hospital is a flagship hospital of India’s foremost healthcare groups,the Apollo Group. It is a highly renowned multi-speciality facility that offers tertiary and quaternary care services to domestic and international patients.
- The 900 bedded hospital is outfitted with the most modern technology for diagnostics as well as therapeutic purposes.
- A team of highly trained medical professionals work under all the 52 specialities at the hospital.
Max Super Specialist Hospital Saket
Number of beds: 500
ICU Beds: 267
Airport Distance: 13 KM
Brief About:
- Max Super Speciality Hospital at Saket is one of the topmost healthcare service
- Providers in India. The multi-super speciality hospital has a capacity of over 500 beds, 250 functional beds. It is equipped with state-of-the-art facilities, advanced technologies.
- With the help of over 300 leading specialist Doctors, strong nursing staff, and state-of-the-art innovative medical tools.
Artemis Hospital Gurgaon
Number of beds: 600
ICU Beds: 185
Airport Distance: 19 Km
Brief About:
- Artemis Hospital, established in 2007, spread across 9 acres, is a 600plus bed; state-of-the-art multi-speciality hospital located in Gurgaon, India.
- Artemis Hospital is the first JCI and NABH accredited hospital in Gurgaon.
- Designed as one of the most advanced hospitals in India, Artemis provides a depth of expertise in the spectrum of advanced medical & surgical interventions, a comprehensive mix of inpatient and outpatient services.
Medanta The Medicity Hospital
Number of beds: 1250
ICU Beds: 300
Airport Distance: 18 KMs
Brief About:
- Medanta – The Medicity is amongst India’s largest and most renowned multi-super speciality healthcare centre with 1250 beds, 29 super speciality units and more than 800 accomplished doctors.
- Supported by state-of-art infrastructure, all the departments in the hospital are fully equipped with cutting-edge technology, modular Operation Theatre and modernized monitoring systems in ICUs.
- The panel of doctors from Medanta, headed by A.S.Soin performed the first successful intestinal transplant in India.
Treatments
Mastectomy Surgery cost in India
Robotic Prostate Surgery in India
Hysterectomy Surgery Costs In India
Oophorectomy cost in India
Colostomy Surgery in India
Thyroid Surgery Cost In India
Esophageal cost in India
Gastrectomy cost in India
Whipple Procedure cost in India
Cholecystectomy Surgery Cost in India
Sentinel Lymph Node Biopsy cost in India
Bone Marrow Transplant cost in India
Gastrointestinal Anastomosis cost in India
Limb Amputation cost in India
Retroperitoneal Lymph Node Dissection (RPLND) cost in India
Thoracic Surgery Cost in India
Cystectomy cost in India
Lobectomy cost in India
Pneumonectomy cost in India
Glossectomy cost in India
Laryngectomy cost in India
Cholecystectomy cost in India
Pancreatectomy cost in India
Splenectomy cost in India
Hepatectomy cost in India
Adrenalectomy cost in India
Treatment Bone Cancer
Mohs Surgery cost in India
Precision of Pelvic Laparoscopy
Transurethral Resection of Bladder Tumor (TURBT) cost in India
Transoral Robotic Surgery (TORS) cost in India
Get Opinion From Doctor
We offers these Services
- Providing a doctor’s opinion and proper quotation
- Selecting the best hospital and doctor as per your case
- Arranging a call with the doctor (if the case required)
- Visa assistance, Providing Visa Invitation Letter (VIL)
- Providing full guidance how to get Visa from your country
- Providing total cost including treatment, air tickets, accommodation, and food
- Assitance to book flight ticket from your country
- Arranging airport pick up/ drop
- Providing professional language interpreter
- Booking accommodation and guest house as per your budget/ prefrence
- Providing help in money exchanging
- Providing local sim card
- Arranging video consultation with specialist doctor if case requires
Fortis Memorial Research Institute
Number of beds: 1000
ICU Beds: 298
Airport Distance: 17 KMs
Brief About:
- Fortis Memorial Research Institute was established in 2001.
- It is an outstanding multi-speciality quaternary care hospital,having the top-notch infrastructure, advanced equipment, highly qualified and experienced medical professionals and super sub-specialists.
- Fortis Hosptial Gurgaon is an advanced centre of excellence in Robotic Surgery, Neurosciences, Oncology, Renal Sciences, BMT, Organ Transplants, Orthopaedics, Cardiac Sciences and Obstetrics & Gynaecology.
SHALBY Sanar International Hospital
Number of beds: 130
ICU Beds: 35
Airport Distance: 20 Km
About Hospital:
- SHALBY Sanar International Hospital was established in 2018.
- SHALBY Sanar International Hospital founded by Mr. Naresh Kapoor.
- SHALBY Sanar International Hospital offers comprehensive advanced surgical care in specialties like Cancer, Heart, Blood and Marrow Transplant, Lung, Liver, and Neurosciences along with other major departments with advanced state-of-the-art facilities.
Marengo Asia Hospital
Number of beds: 110
ICU Beds: 31
Airport Distance: 19 KMs
About Hospital:
- Established in 1995, Marengo Asia Hospital is a 110+ bedded flagship hospital of the Pratiksha group.
- Marengo Asia Hospital in Gurgaon, the flagship hospital of Pratiksha Group is a one-of-its-kind facility in Gurgaon that brings to you 30 years of experience.
- The hospital has treated more than 25,000 people In 2018.
Accord Superspeciality Hospital
Number of beds: 380+
ICU Beds: 41
Airport Distance: 46 Km
About Hospital:
- The story of Accord began with the thought of leveraging the new age technology with the healthcare infrastructure to serve the patients, rightly, effectively, and timely.
- Accord Superspeciality Hospital (A Unit Of SCL Healthcare Pvt. Ltd) is India’s first smart hospital and one of the first of its kind in the world.
- Accord Superspeciality Hospital aims at providing technologically advanced healthcare services to international patients who are looking out for medical tourism in India.
CK Birla Hospital
Number of beds: 75
ICU Beds: 15
Airport Distance: 20 Km
About Hospital:
- CK Birla Hospital is a part of $1.8 billion diversified and one of India’s most popular business houses- CK Birla Group
- The CK Birla Hospital for Women aims to improve the quality of healthcare with an emphasis on UK NHS guidelines for nurse and midwife training with policies and protocols adapted from UK’s National Institute for Health & Care Excellence (NICE) guidelines.
- Our state-of-the-art technology and facilities which have been set up by a team of international consultants.
- The hospital, spread over 78,000 sq ft having spacious patient rooms and suites with all amenities, outpatient rooms, advanced labour and recovery rooms, state-of-the-art diagnostics, physiotherapy unit, an advanced IVF unit with a modular egg collection theatre, andrology lab, IVF lab, IUI/embryo transfer facility and a cryo store.
Get Opinion From Doctor
We offers these Services
- Providing a doctor’s opinion and proper quotation
- Selecting the best hospital and doctor as per your case
- Arranging a call with the doctor (if the case required)
- Visa assistance, Providing Visa Invitation Letter (VIL)
- Providing full guidance how to get Visa from your country
- Providing total cost including treatment, air tickets, accommodation, and food
- Assitance to book flight ticket from your country
- Arranging airport pick up/ drop
- Providing professional language interpreter
- Booking accommodation and guest house as per your budget/ prefrence
- Providing help in money exchanging
- Providing local sim card
- Arranging video consultation with specialist doctor if case requires











